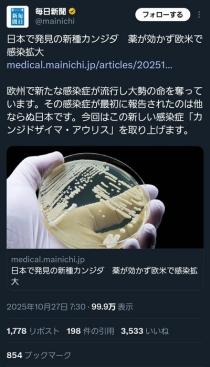

新着順

11/03 08:00

11/03 07:00

11/03 06:00

11/03 00:02

11/02 22:42
11/02 22:20

11/02 21:27

11/02 21:03

11/02 11:00

11/02 10:00

11/02 09:00

11/02 08:00

11/02 07:00

11/02 06:04

11/01 22:30

11/01 21:23

11/01 20:25

11/01 19:51

11/01 09:00

11/01 08:00

11/01 07:14

11/01 06:21

10/31 22:30

10/31 22:30

10/31 22:12

10/31 22:12

10/31 21:24

10/31 21:24

10/31 20:01

10/31 10:00

10/31 09:00

10/31 08:00

10/31 07:00

10/31 06:00

10/31 05:00

10/30 23:02

10/30 22:40

10/30 21:38

10/30 21:20

10/30 20:48

10/30 20:21

10/30 11:00

10/30 10:00

10/30 09:00

10/30 08:00

10/30 07:00

10/30 06:37

10/29 22:35

10/29 20:27

10/29 11:00
